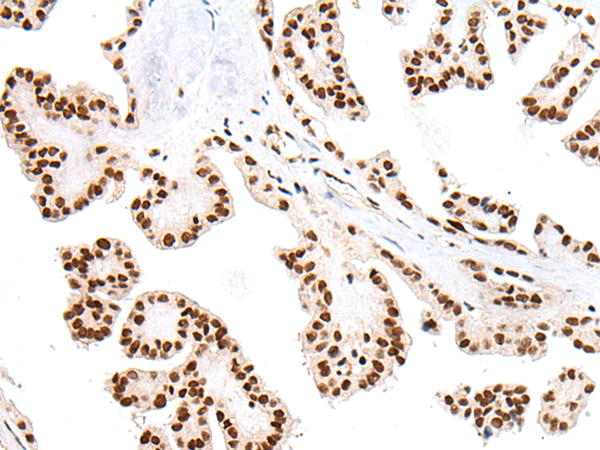

中文名稱: 兔抗PTOV1多克隆抗體
英文名稱: Anti-PTOV1 rabbit polyclonal antibody
別 名: ACID2; PTOV-1
相關(guān)類別: 一抗
儲(chǔ) 存: 冷凍(-20℃)
宿 主: Rabbit
抗 原: PTOV1
反應(yīng)種屬: Human, Mouse, Rat
標(biāo) 記 物: Unconjugate
克隆類型: rabbit polyclonal
技術(shù)規(guī)格
|
Background: |
This gene encodes a protein that was found to be overexpressed in prostate adenocarcinomas. The encoded protein was found to interact with the lipid raft protein flotillin-1 and shuttle it from the cytoplasm to the nucleus in a cell cycle dependent manner. Alternative splicing of this gene results in multiple transcript variants. |
|
Applications: |
ELISA, WB, IHC |
|
Name of antibody: |
PTOV1 |
|
Immunogen: |
Synthetic peptide of human PTOV1 |
|
Full name: |
prostate tumor overexpressed 1 |
|
Synonyms: |
ACID2; PTOV-1 |
|
SwissProt: |
Q86YD1 |
|
ELISA Recommended dilution: |
5000-10000 |
|
IHC positive control: |
Human lung cancer and human thyroid cancer |
|
IHC Recommend dilution: |
25-100 |
|
WB Predicted band size: |
47 kDa |
|
WB Positive control: |
Rat brain tissue and Mouse brain tissue |
|
WB Recommended dilution: |
200-1000 |

購物車
幫助
021-54845833/15800441009
